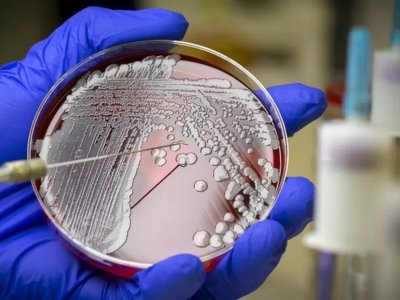

Штучний інтелект допоміг вченим відкрити новий надпотужний антибіотик
- Останні
- Популярні
Більше новин
Більше новин
Новини по днях
Сьогодні,
9 травня 2025
9 травня 2025
Інші новини
Більше новин